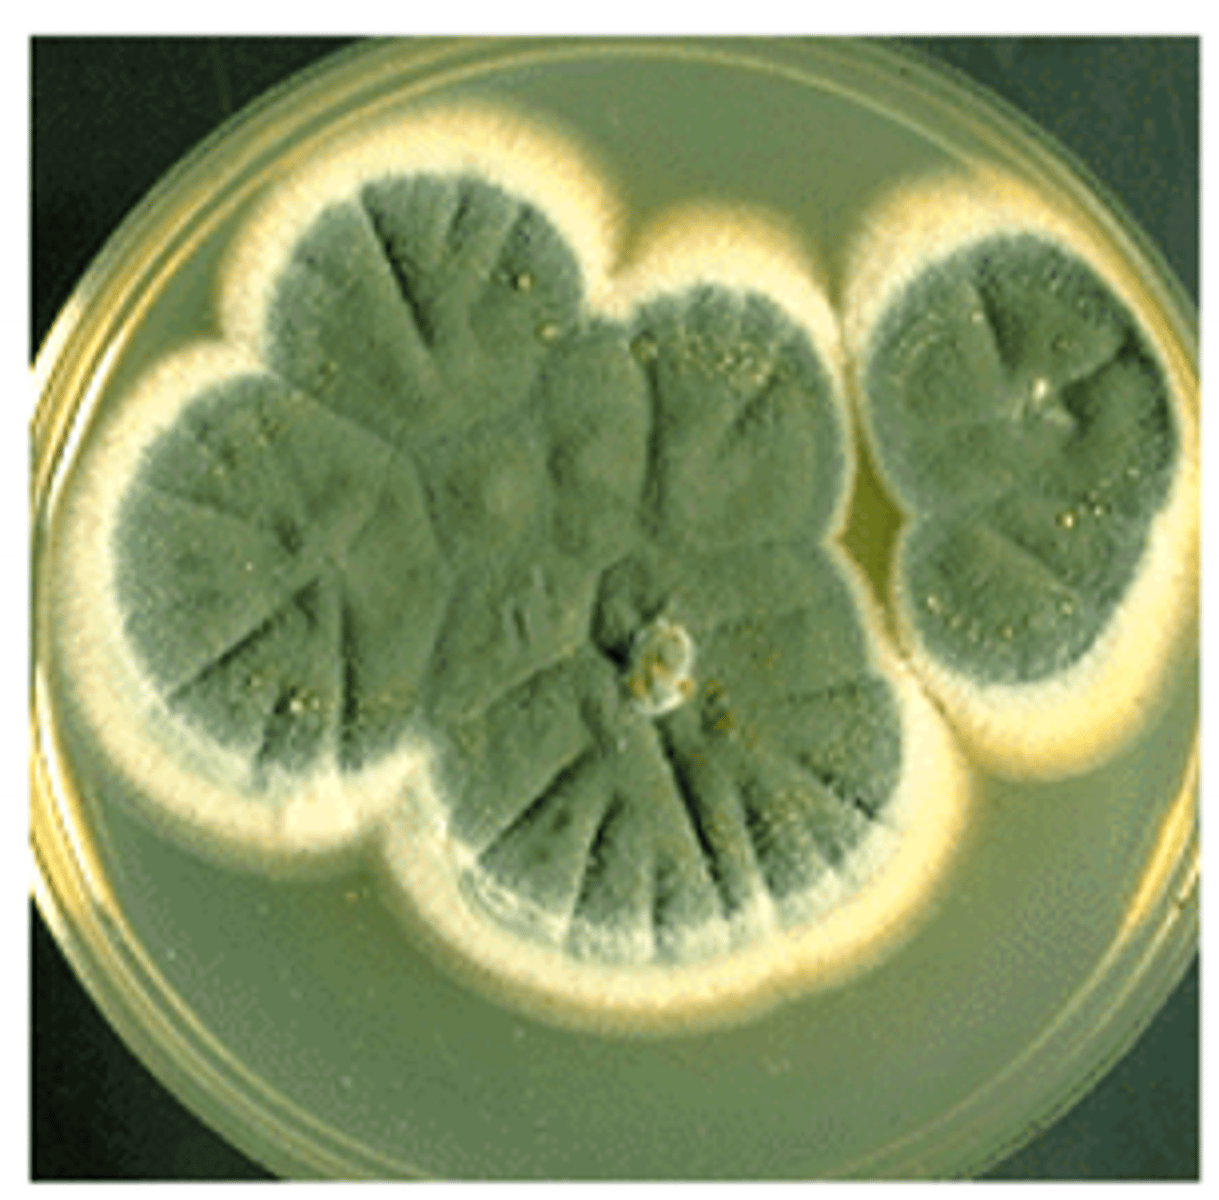
<p>appear to have more textures and pigments; identify with observation</p>
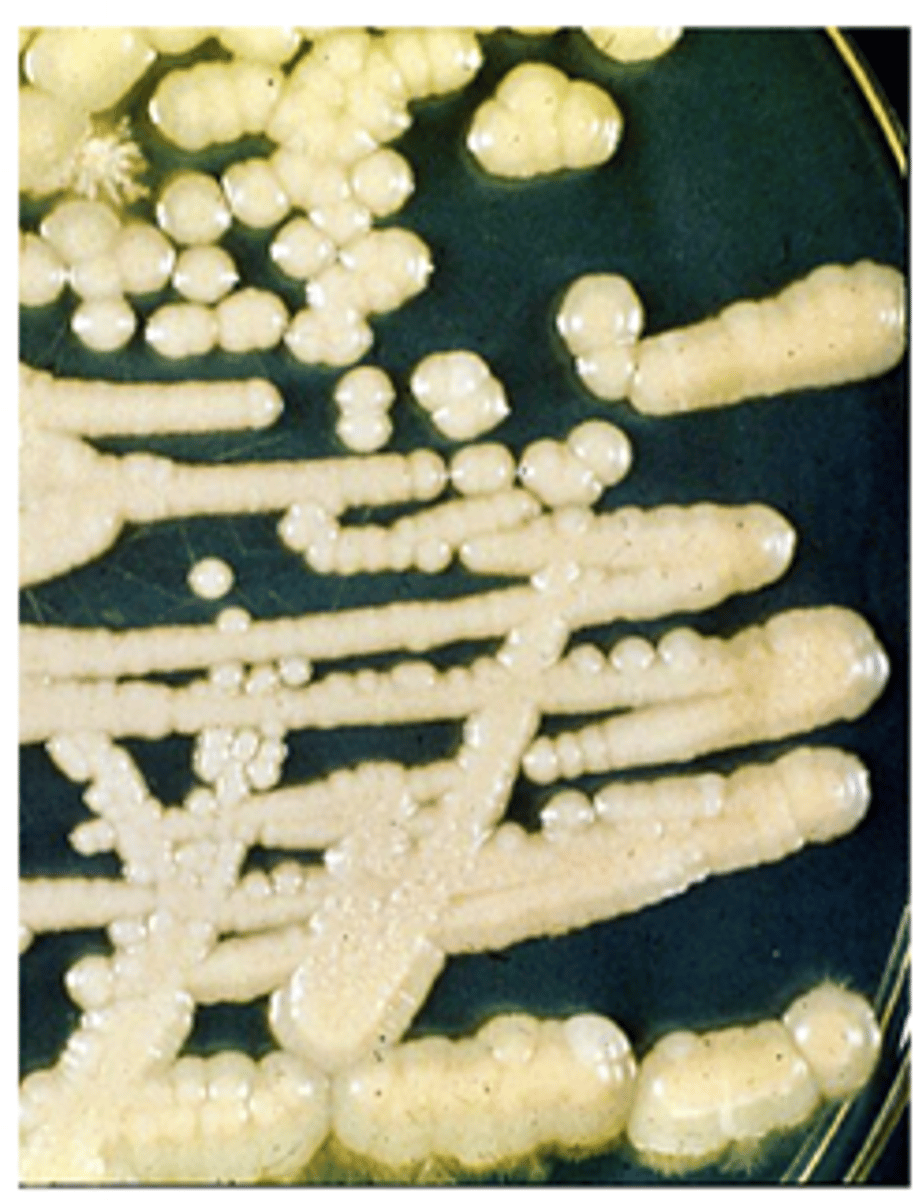
<p>appear creamy and glabrous; identify with biochemical tests</p>
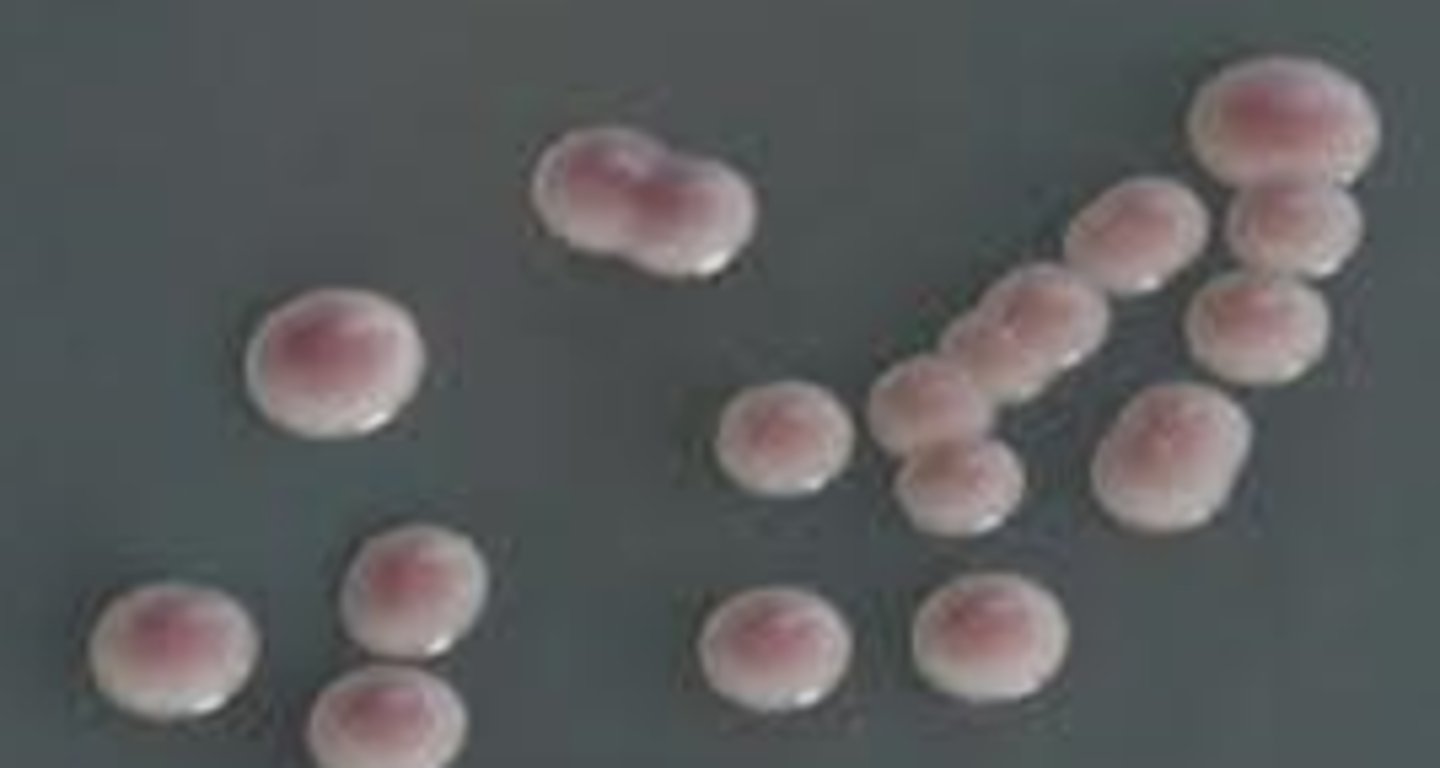
<p>· Potential induction of fluconazole resistance upon suboptimal treatment</p><p>· colony forming units on eosin methylene blue agar are larger</p><p>· Small blastocondida; may bud at 11:00 and 1:00 (mickey mouse)</p><p>· “distinctive” morphology on chromogenic medium</p><p>· Rapid trehalose testive gives presumptive ID within 3 hours </p>

Anaerobes and Medical Mycology
1/70
There's no tags or description
Looks like no tags are added yet.
Name | Mastery | Learn | Test | Matching | Spaced | Call with Kai |
|---|
No analytics yet
Send a link to your students to track their progress
71 Terms
obligate aerobes
bacteria that only grow in the presence of oxygen (21%)
Ex: pseudomonas, bacillus
facultative
bacteria that can grow in both aerobic and anaerobic conditions
Ex: enterobacterales, staphylococci, streptococci
Microaerophilic
bacteria that are close to being anaerobic; grow in 5% oxygen
Ex: campylobacter
Capnophilic
bacteria that require less oxygen but love growing in carbon dioxide (5-8%)
Ex: strep pneumoniae, neisseria (especially gonorrhoea), haemophilus
obligate anaerobe
bacteria that require very trace amounts of oxygen or no oxygen at all (3%)
good specimen sources for anaerobes
Ex: fluids/aspirates, deep abscesses, biopse, direct lung aspirates
bad specimen sources for anaerobes
Ex: gingival crevices, throat/nasopharyngeal swabs, sputum/BAL, gastric contents, feces/rectal swabs, voided urine, cervical/vaginal swabs, surface of ulcers or wounds
anaerobes
CDC blood agar is non-selective for growth of all _________________
gram-negative facultative
phenylethylalcohol agar inhibits _________________
B. fragilis
bacteroides bile esculin agar selects for
anaerobes (especially acintomyces) and facultative
thioglycolate broth selects for _______________
anaerobes (especially chlostridium)
cooked meat glucose broth
B. fragilis
Reservoir: lower GIT normal flora
infections: bloodstream, wound, abscess, intra-abdominal, appendix, bone
Most common anaerobe isolates
screen with Bile tolerance test

fusobacterium
· Reservoir: oral cavity and lower GIT
· Infections: recurrent tonsillitis, pharyngitis, Lemierre's syndrome, bacteremia

clostridiodes difficile
· Reservoir: lower GIT
· Infections: antibiotic-associated diarrhea; pseudomonas colitis
· Worry more about the toxin than the bug itself
clostridium perfringenes
· Reservoir: marine and terrestrial environment; GIT
· Infections: gas gangrene; gastroenteritis

chlostridium tetani
· Reservoir: soil, dust, manures; vaccine-preventable illness
· Infections: tetanus (rigid paralysis); potential mortality due to asphyxiation

clostridium botulinum
· Reservoir: environment
· Infections: wound botulism, infant botulism, flaccid paralysis, potential mortality due to diaphragm deficit covert bioterrorism
· Don’t give babies unpasteurized honey

B. fragilis, fusobacterium
gram negative anaerobes
Clostridioides, clostridium
gram positive anaerobes
chronic
fungal infections are generally more __________ than accute
iatrogenic
most fungal infections are ______________ and generally involve a predisposition that suppresses the immune system
signal disease
Candida albicans, Cryptococcus neoformans, and Pneumocystis jirovecii infections can be a _________________________ for an immune deficiency
25C
ideal growth temperature for mold
37C
ideal growth temperature for yeast
mold
appear to have more textures and pigments; identify with observation
yeast
appear creamy and glabrous; identify with biochemical tests
hyphae
basic unit (single cell) of molds
blastoconidium
basic unit (single cell) of yeast
4 weeks
test time for mold: report negative at _____________
overnight
test time for yeast
non-selective
sabourad dextrose agar
opportunists
Chloramphenicol and cycloheximide selective media inhibit ___________
mycobaiotic agar
Sabouraud dextrose with antibiotics - chloramphenicol + cycloheximide
2
pathogenic molds take _____ or more weeks to grow
mycobiotic
Nastier the mold = longer it takes to grow and more likely to grow on ___________ agar
mannoproteins
fungal protein that is located on the surface of the cell wall
B-glucans
polysaccharide in fungal outer membrane between chitin and mannoproteins
chitin
provides both toughness and flexibility in the fungal outer membrane
opportunists
hyaline molds, mucormyctes, and yeasts are subdivisions of ___________
aspergillosis
must come from nasoorbital, endocardial, cutaneous, disseminated, CNS, or pulmonary pathologies
aspergillus fumigatus
· Maturity ~3 days
· Colony surface becomes dark greenish to gray; reverse white to tan; inhibited by cycloheximide
· Composed of stalk (forearm), vesicle (fist) and phialides (hair)
· Conidiophores short and smooth
· Phialides on upper 2/3 of vesicle --> mohawk haircut

aspergillus flavus
· Commonly associated with aflatoxins
· Colony surface velvety, yellow to green or brown; reverse white to tan; inhibited by cycloheximide
· Conidiophores rough and spiny
· Phialides covering entire vesicle (all directions) --> afro haircut

Fusarium
· Common contaminant: mycotic keratitis (#1), disseminated disease
· Maturity in about 4 days (quick grower)
· Cottony surface, develops violet or pink center with light periphery; reverse light; inhibited by cycloheximide
· Canoe-shaped macroconidia ± 1 to 2-celled conidia in clusters

Mucor
· Common contaminant
· Lid lifters
· Maturity in about 4 days; growth inhibited by cycloheximide
o Rapid growers
· Cottony or moist surface, becomes grey; reverse white
· Rhizoids absent
haircut: Don King the boxing promotor

mucormycosis
· Diabetic susceptibility and high mortality rate
· Orbital mucor myotic infections
Rhizopus
· Common contaminants
· Maturity in about 4 days; growth inhibited by cycloheximide
· Cotton candy – white at first, then grey or yellowish brown; reverse white
· Rhizoids are opposite of sporangiophores

Candida albicans
· Normal flora (small numbers) in skin, vagina, oral cavity, and intestine
· Finger-like or star-like projections on blood agar
· Most common species isolated from all forms of candidiasis
· Contiguous germ tube formed from incubation of colony in serum
· Distinctive morphology on chromogenic medium
· Terminal chlamydocondia, especially at 25C

c. albicans
causes thrush, vaginitis, onychomycosis, skin infection, and fungemia - immunocompromised patients, those with indwelling catheters, those on broad-spectrum antibacterial are most susceptible
candida glabrata
· Potential induction of fluconazole resistance upon suboptimal treatment
· colony forming units on eosin methylene blue agar are larger
· Small blastocondida; may bud at 11:00 and 1:00 (mickey mouse)
· “distinctive” morphology on chromogenic medium
· Rapid trehalose testive gives presumptive ID within 3 hours
c. glabrata
causes endocarditis, meningitis, multifocal disease, and makes up 20% of candida UTIs
cryptococcus neoformans
· Signal disease for HIV or Kaposi sarcoma
· Tinkertoy structure

pneumocystis jiovecii
· Serology, nucleic acid detection not useful
· Cyst wall, intracystic body stains

pathogenic
dimorphs and dermatophytes are subdivisions of _____________ molds
dimorphs
-have two growth phases (mold and yeast)
-geographic distribution helps with diagnosis
-produce multi-focal clinical disease (most respiratory, some cutaneous, CNS, bone, reticuloendothelial)
-morphology mimics non-pathogenic fungi so extra measures must be taken to conform
mold, yeast
to identify dimorphs, convert __________ to ________ by subculturing in blood media at 37C
opportunistic
Aspergillus, Fusarium, Mucor, Rhizopus, Candida, Cryptococcus, and Pmeumocystis are ______________ molds
pathogenic
Histoplasma, Blastomyces, Coccidiodes, and Dermatophytes are ______________ molds
dimorph
Histoplasma, Blastomyces, and Coccidioides are examples of ______________ pathogenic molds
histoplasma capsulatum
· soil with starling, bat guano; inhalation
· Tuberculate macroconidia
· small, budding yeast; loves macrophages
· Bob Dylan
· Breathe in as mold --> turns into yeast

histoplasmosis (Darling's Disease)
subacute self-limited respiratory illness (like TB); disseminates to liver, spleen, and brain

Darling's disease
Histoplasmosis
Blastomyces dermatitidis
· Soil (alkalinity, moisture, organic matter); inhalation
· Lollipop (single) conidia, at top of conidiophores
· Big, broad -based buds of Blasto

Blastomycosis (Gilchrist's Disease)
o 50% asymptomatic, self-limiting
o Lower respiratory disease
o Disseminate to skin, bone, prostate
Gilchrist's Disease
Blastomycosis
coccidiodes immitis
· Hot, dry, alkaline soil; wind, construction; inhalation
· Barrel-shaped, alternate arthroconidia
o May grow quicker than other dimorphs
· No yeast form; spherule in vivo

coccidioidomycosis (Valley Fever)
o 60% asymptomatic, self-limiting
o Lower respiratory disease
o Rate dissemination to skin, bone, joints (Filipino, African, Asian, Mexican)
o CNS in AIDS patients (#3; devastating)
Valley Fever
Coccidioidomycosis
dermatophytes
· Infrequent mortality
· Tinea (ringworm)
· Immunocompromised host not required (anyone can get athletes foot or jock itch)
· #1 infectious disease
trichophyton
causes tinea capitis, and tinea pedis
trichophyton rubrum
#1 dermatophyte in humans